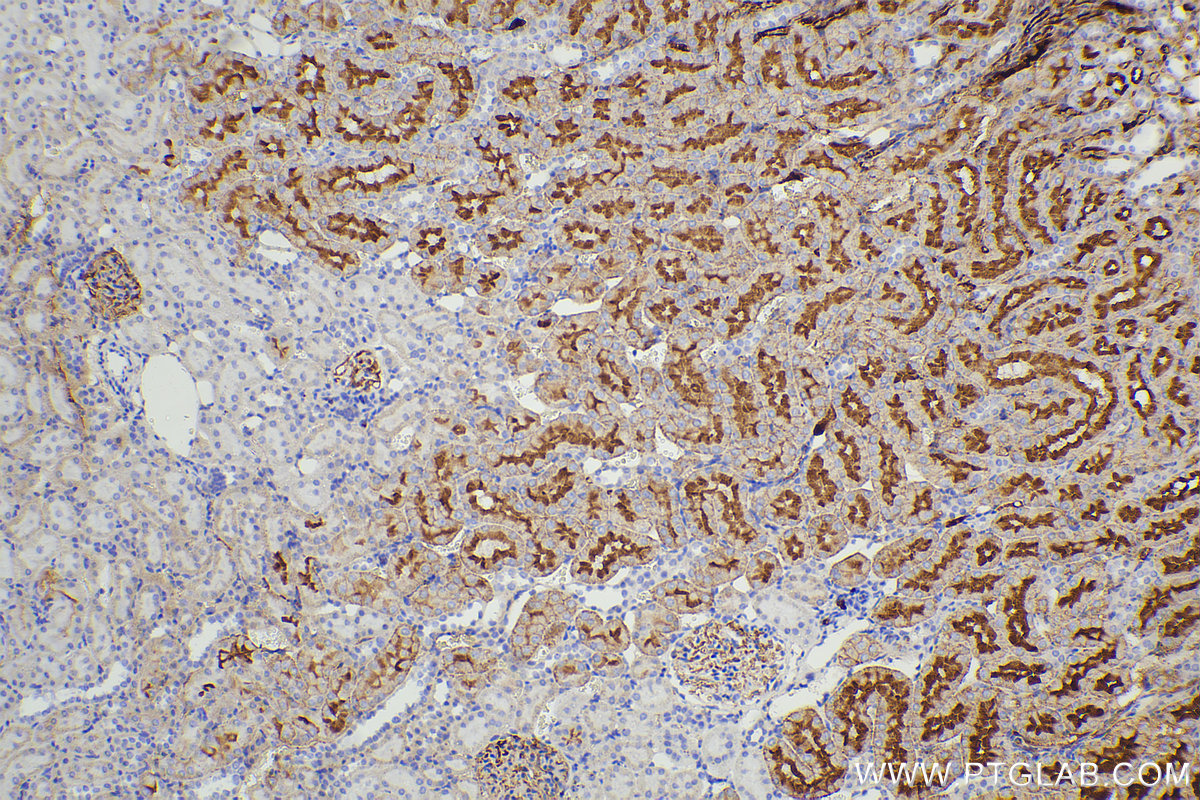

Validation Data Gallery
Product Information
RGAM011 targets Mouse IgG (H+L) in IHC. It can bind to all mouse IgG isotypes, mouse IgM and IgA as well as rat IgG. It shows minimal reactivity for rabbit, human, pig and bovine IgGs.
| Concentration | Ready to use |
| Applications | IHC |
| Host Species | Goat |
| Species Reactivity | Mouse |
| Physical State | Liquid |
| Suggested Dilution Range | Ready to use |
| Purity | Protein G purification |
| Storage Buffer | TBST+10 mg/mL BSA+1 mg/mL gelatin + 0.1% proclin300 |
| Storage Instructions | Store at 2-8°C. Stable for one year after shipment. |
| Clonality | Multiclonal recombinant |
| RRID | AB_3094533 |
| Note | This product is for research use only,not for diagnostic or therapeutic use. |
背景介绍
Multi-rAb™ Polymer HRP-Goat Anti-Mouse Recombinant Secondary Antibody (H+L) enables highly sensitive, biotin-free detection of mouse primary antibodies in IHC. Unlike traditional avidin-biotin-based signal amplification methods, polymer HRP-based detection offers the advantages of a lower background and faster protocol with fewer steps. Moreover, Multi-rAb™ Polymer HRP secondary antibodies are provided in a ready-to-use format, in easy-to-use dropper bottles making it extremely convenient for users to incorporate them into their IHC staining protocols.
Publications
| Title |
|---|
Transl Oncol METTL3 methylated KIF15 promotes nasopharyngeal carcinoma progression and radiation resistance by blocking ATG7-mediated autophagy through the activation of STAT3 pathway |
Front Bioeng Biotechnol RGDSP-functionalized peptide hydrogel stimulates growth factor secretion via integrin αv/PI3K/AKT axis for improved wound healing by human amniotic mesenchymal stem cells |
Front Oncol Identification of immune-associated genes for the diagnosis of ulcerative colitis-associated carcinogenesis via integrated bioinformatics analysis |
Drug Resist Updat TMOD3 accelerated resistance to immunotherapy in KRAS-mutated pancreatic cancer through promoting autophagy-dependent degradation of ASCL4 |
J Control Release Mannose-modified exosomes loaded with MiR-23b-3p target alveolar macrophages to alleviate acute lung injury in Sepsis |
BMC Oral Health High glucose induces senescence in synovial mesenchymal stem cells through mitochondrial dysfunction |